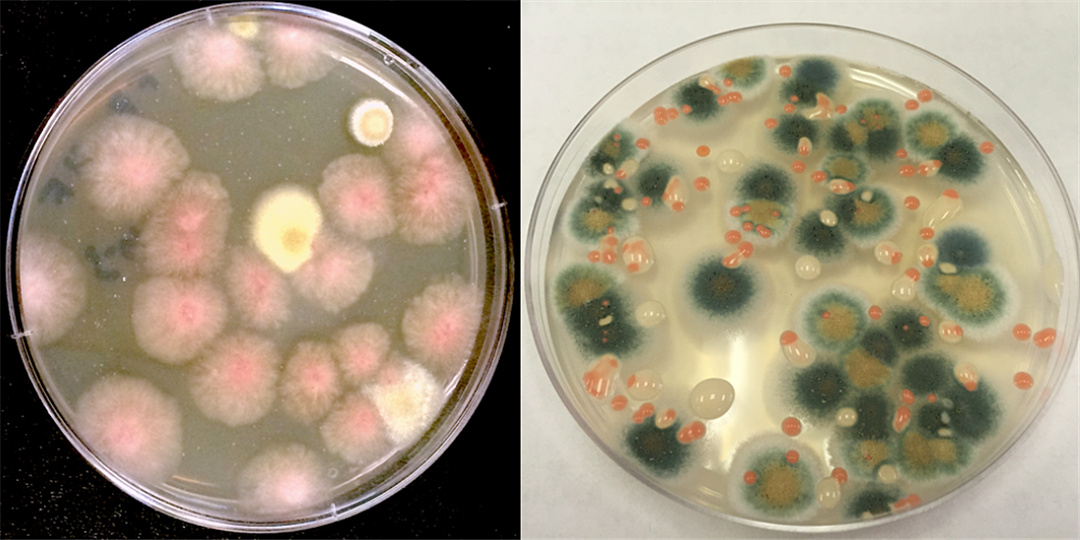
科普在太空种菜的诸多学问,太空上为什么能种菜呢

我们为种菜而生
我们中的大多数人喜欢侍弄一些花花草草。若有幸生活在农村,那一定是要刨上几垄地种上蔬菜,以满足日常口腹所需;而要是在城市里,有一个大院子,除了在角落种几颗葱或大蒜外,八成还会栽培几棵树木、搭个葡萄架;没有院子的会在阳台上放几盆花儿,记起来的时候浇浇水剪剪枯叶;若是连阳台都没有,也多半会在案头摆一株盆栽,或是插两支绿萝。总之,我们的眼前不能少了绿色,那意味着生机,是生命的颜色。

在花园里种菜是一种时尚
然而那些亿万人羡慕的太空人、那些工作在数百公里高空的宇航员们就难有这般幸运,他们连吃一盘新鲜的炒青菜都做不到,更别说去阳台侍弄花草了。
并不是说宇航员们都摆脱了人间的“低级趣味”,也非忙到无暇栽花种草,而是在太空种菜的确很难。难在哪里?且听我一一道来。
微重力环境
太空的微重力环境是空间站的优势所在,却也是植物生长的最大障碍。
我们生活在地球上,由于地面上的万物皆有质量,地球也是个有着庞大质量的星球,于是地球对所有的东西都有吸引力,这就是重力。你吃的越多,你就越重,这是大家都懂的道理,于是人人都羡慕那些吃不胖的人。
有许多科学研究不希望有重力参与,比如说在晶体的生长过程中,重力是一个额外的、破坏性的力。重力常常会拉扯分子,使结晶变得不完美。而在无重力的环境中,由于各个方向力大致相同,我们就比较容易得到完美的结晶体。

在空间站得到的蛋白质结晶
万有引力与质量相关,也跟两个物体的相互距离相关,要想将地球引力减小100万倍,我们需要跑到距离地球600万公里的地方,想回家一趟很难。不过我们可以通过围绕地球做快速圆周运动来模拟微重力环境,当圆周运动产生向外的惯性力与地球引力相互抵消,我们就可以得到一个近似的失重状态。实际上包括国际空间站在内的绝大多数人造航天器都处于这样的微重力状态,它们既不会飞走,也不容易掉下来(当然最终还是会掉下来)。

在近地轨道飞行的空间站制造了微重力环境
失重对植物有什么影响?
这影响大了。
经过数千万年的演化,几乎所有的植物都适应了地球表面的重力环境,它们并不是为失重而生的。
- 蒸腾作用
植物在生长过程中需要将矿物质和营养元素从根部通过茎输送到叶子、花朵和果实,以满足所有细胞的代谢需要。这个过程通过植物的蒸腾作用来完成:叶片上的微小气孔通过散发水蒸气,内部渗透压的改变使植物内部产生负压,从而驱动根部的水携带着养分沿着毛细管道一路上行到达需要的地方。

植物蒸腾作用
蒸腾作用的强弱与温度、相对温度以及空气流动的速度有关。由于在太空微重力环境下没有空气对流,叶片蒸发出来的水汽会聚集在植物周围,甚至就吸附在叶片表面完全堵塞住所有的气孔,蒸腾作用无法进行下去,植株得不到营养,植物就会被自己“淹死”。

植物蒸腾的水量很大
- 光合作用
光合作用是植物将光能转化为化学能的过程。在阳光的照射下,植物通过叶绿素将水分解为氢和氧,同时吸收空气中的二氧化碳,将其与氢组合成糖,以为植物生长提供营养,多余的氧气被释放到空气中。这个过程一般表示为下面的方程式:
CO2 + 2H2O + 光子的光能 → [CH2O]碳水化合物 +O2 + H2O

植物光合作用
由此我们看出,植物的光合作用需要阳光、二氧化碳和水,同时排出氧气。地面的阳光与太空中的阳光不是一回事,由于厚厚的大气层吸收了太阳光中大量的紫外线、x射线、γ射线和其它高能粒子,地面的阳光没有什么*伤杀**力。但在大气层之外,阳光的直射可以轻易杀死任何一株植物。
与蒸腾作用遇到的麻烦相同,由于在太空中没有空气对流,植物叶片散发的氧气会包裹在植株周围形成氧气“墙”,二氧化碳进不来,于是植物无法继续进行光合作用,它会被“憋死”。

在空间站种植实验的植物
当然以人类的聪明才智,以上两点都不是问题,只要做好通风就可以解决。通过持续向植物送风,在其周围形成空气对流,将水气和氧气吹走,植物就可以得到它所需要的二氧化碳和养料。

空间站已经种出了小麦
更大的问题在于种植它们需要很多的电、很多的水、矿物质肥料、干净的空气和一块很大的地方。这将极大地加重航天器的负担。
- 电能供应
与地面种菜不同,在太空中种菜、养花花草草是需要耗电的。因为阳光不能用,我们需要合适的灯光来照射它们以完成光合作用;我们还需要一刻不停地向它们鼓风;我们需要额外过滤空气和水。这一切都依赖复杂的设备和电能的供应。

空间站为种菜重金打造的复杂设备
- 灌溉的难题
为阳台上的盆栽浇水只需要几秒钟的时间,但在太空中你需要持续不断地浇水——这需要用到专门开发的滴灌技术,因为太空是微重力的。
植物在生长期内的蒸发量很大,据统计,1平方米玉米地的玉米每天会蒸发掉3.7升的水,你需要在保持持续为根系供水的同时,将植株蒸发的水气收集起来重复使用。在太空中,水是极宝贵的资源,它比油贵多了。

宇航员正在浇灌生菜
- 合理施肥
在太空中,土壤是不能用的。尽管我们周围的土壤富含矿物质和植物生长必须的各种有机质,但它同时也含有数不清的细菌、真菌和其它有害物质。在太空狭小的环境中,这些东西可能会让宇航员生病甚至致命。所以在太空中种菜需要经过精心筛选的种子、特制的基质和专门配制的营养素,它们都不便宜。

专门配置的营养硅藻土
- 空气过滤
说出来你可能不信,空间站里的空气并不如你想象的那样新鲜。这里的二氧化碳浓度比地面要高10倍,并且其中还含有更多的氨气、*酮丙**、甲醇、甲醛等等气体,这些气体大多通过宇航员呼吸或肠道排出,有一些是运行的设备排放到空气中,而气体过滤设备并不能完全清除它们。虽然二氧化碳对植物有益,但其它一些气体对植物正常生长有害。

这样一套空气过滤装置拿来种菜肯定是不够用的
- 宝贵的空间
比起水、电、肥和空气更贵的,是要在空间站开辟出一块足够大的菜园地,来满足宇航员们的胃。要做到这一点跟登天一样难。一个专门为种植蔬菜而设计的太空舱可能要花费数十亿美元来设计建造,再花数亿美元将它发射上天,将来对它的维护还将花掉更多的钱。

在地面建造的模拟舱
总结:
在植物生长和繁衍方面,有许多力量共同作用于我们这个星球,一旦离开地面,这些平常我们认为理所当然的因素就变得极其重要和昂贵。
人类不断探索在太空中种植蔬菜的技术,一方面为了拯救当下宇航员们的味觉,他们吃了太久塑料袋包装的保鲜食品,同时也希望为未来更遥远的太空旅行创造物质条件。因为即使是拜访距离我们最近的行星,来回也需要几年的时间,食品的保质期很难达到那么久。

宇航员被允许品尝生菜实验样品
但太空种植面临的难题远不止本文中讨论的这些。我们不仅需要花费大量的时间和金钱来解决规模太空种植带来的光、水、电、气、肥等问题,还需要解决植物在太空中的授粉繁殖、空间辐射带来的意外基因突变、有害微生物不受控制地滋生繁殖等等问题。
这是从空间站采集到的细菌和真菌
总之,人类对宇宙的探索永不止步,太空种菜任重道远。好在我们已经迈出了第一步,还将继续走下去。